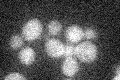
YDR475C
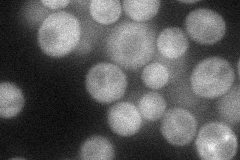
YDR475C
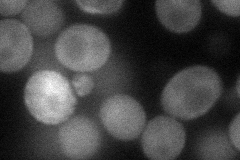
YDR475C
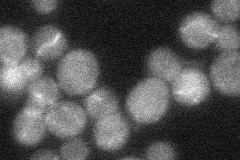
YDR475C
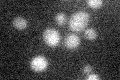
YDR475C

View description
Protein of unknown function; previously annotated as two separate ORFs, YDR474C and YDR475C, which were merged as a result of corrections to the systematic reference sequence
Localization:
Intensity:
Fold change:
Significance:
-
C’ GFP library in SD
below threshold16.08 -
N' NOP1pr-GFP in SD
cytosol,cell periphery51.7269 -
N' TEF2pr-mCherry in SD
cell periphery51.5315 -
N' NATIVEpr-GFP in SD
below threshold30.0794 -
N' TEF2pr-VC and Cyto-VN in SD

cytosol29.3654 -
C’ GFP library in SD+DTT

cytosol17.831.1No -
C’ GFP library in SD+H2O2

cytosol16.461.02No -
C’ GFP library in Starvation Media
cytosol18.231.13No -
C’ GFP library on the background of Pup2-DaMP

below threshold -
C’ GFP library on the background of CCT mutant

below threshold15.77730.980668No
